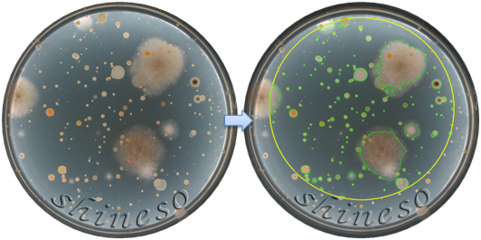

抗癌饮食
抗癌饮食详细为您提供抗癌食物有哪些等信息。其中详细提供吃什么可以预防癌症?哪些膳食习惯容易惹来癌症?日常生活中哪些饮食习惯容易致癌?癌症患者的饮食有什么注意?
*以上解读内容仅供参考,癌症123不对解读内容负责。
专家介绍肺癌饮食的注意事项
2017-01-13肺癌患者应忌腥油腻食品,忌讳辛辣和烟、酒等刺激性食品。要破除迷信,走出饮食误区,不能只喝汤不吃渣,营养大多在渣里,汤的营养只有原料的5%~10%;不能只吃肉不吃菜、不吃鸡蛋。不能只吃菜不吃饭;不能只吃水...
常吃6种水果远离乳腺癌
2017-01-13远离乳腺癌的水果1、芒果科学研究发现,女性多食芒果,有预防乳腺癌的作用。研究人员对芒果中的多酚进行了研究,特别是其中的生物活性成分丹宁(与癌症的预防和抑制有关)。丹宁酸是种多酚,带有苦味,葡萄籽和...
食用过量食盐会引发胃癌
2017-01-13养生警惕:四类隐形盐或诱发胃癌隐形盐之一:快餐现在的小孩,很少有不喜欢吃鸡翅、比萨饼、薯条等快餐食物的。这些都是高盐食物。快餐之所以含盐量高,是因为有各种高盐作料。隐形盐...
合理膳食可以延缓癌症
2017-01-13医生介绍说,烧烤类食物、咸腌制品、熏制食品、油炸食品及霉变物质等均为对人体有致癌或促癌作用的食物;洋葱类、荚豆类、谷类、水果、番茄、马铃薯以及白菜、坚果和种子类食物,则具有抗癌、抑制癌症等作用,...
1类家常饭菜是防癌佳品
2017-01-13新鲜果蔬防胃癌、食道癌新鲜果蔬中含有丰富的维生素C,维生素C具有较强的抗氧化性,维生素C的合理摄入,有助预防胃癌。这可能是因为,维生素C能抑制亚硝酸盐转变成亚硝胺,而亚硝胺是胃癌的诱因之一。...
吃货们谨防“舌尖上的癌症” 饮食得当让患癌风险降40%
2017-01-13都说祸从口出,病从口入。现在大家都知道不健康的生活方式和习惯导致了高血压、糖尿病等各种慢性病,其实不良生活方式尤其是饮食不当更相当于给癌症这趟危险列车加了速。近日,有新闻报道东莞男...
两吃两不吃有效防肝癌
2017-01-13肝癌是日常生活中最常见的健康杀手,很多人发现患肝癌之后一年内就会死亡。对人们的威胁特别大,生活中积极预防肝癌就显得特别的重要,饮食防癌症是不错的方法,遵循饮食中的原则就能抵抗肝癌袭击...
烧烤食物真的会让我们患癌?
2017-01-13一般情况下人们认为烧烤的食物容易诱发癌症,这部分是由于食物在高温烧烤下会产生一种特殊的致癌分子丙烯酰胺分子,这种分子在其工业形式下具有潜在的毒性和致癌特性,然而目前研究人员并不是很清楚事...
肺癌病人能吃鱼么?均衡饮食有利于肺癌治疗
2017-01-13均衡的营养摄取对于肺癌病人治疗是有利的一些人不在意饮食,导致并从口入的结果,肺癌病人对此一定要引以为戒。肺癌发生与诸多因素都存在直接或间接的联系,它在早期治疗,往往会有较好的疗效,大家要多重视,早...
腌制品最容易导致胃癌 防治胃癌多吃什么蔬菜?
2017-01-13胃癌患者的饮食护理:1、番茄:面对发生胃癌的患者,您就要注意采用适当的饮食,这样才会帮助您远离胃癌的发生。在营养学分析上,我们可以得知,人体所需的维生素C,其重要来源就是番茄,并且番茄在储存和烹调的过程...
合理饮食可预防胰腺癌 胰腺癌有什么饮食原则
2017-01-13胰腺癌怎么预防很多中老年人在日常生活中,由于不注意自己的日常运动,很有可能会因为消化不良而患上胰腺癌这种疾病,随着我们生活水平的不断提高,这也使得我们的饮食结构发生了很大的变化,这最近几年患上这...
侵蚀性葡萄胎或绒毛膜癌致子宫穿孔输卵管肿瘤外阴良性肿瘤
2017-01-13预防乳腺癌要做好哪些方面一、不滥用保健品如今面上女性使用的保健品可以说是五花八门,各式各样的,并且由于广告宣传的比较夸张,所以很多女性经受不住诱惑而滥用一些保健品,这样不仅不会保证身体的健...
绿叶菜有防癌作用吗?这样吃蔬菜最健康
2017-01-13绿叶菜如何抗癌?一提绿叶菜,大家就想到了农残、清洗不干净等问题,好像绿叶菜是污染的源头一样。说到抗癌,大家又想到了富含番茄红素的番茄(西红柿)、西兰花等,其实绿叶菜才是最佳防癌蔬菜。1980年,就对绿...
颌骨内肿瘤及埋伏牙颌面部神经纤维瘤颌骨癌
2017-01-13槟榔与口腔癌发病有密切关系,口腔癌有60%左右的患者都和吃槟榔有关。印度是世界槟榔消耗最大国,口腔癌发病率居世界第一。在印度,商业化生产的槟榔果已被要求贴上明显有害警告标签。但在我国,槟榔生产销...
晚饭吃的晚胃癌翻几番 哪些习惯会导致胃癌?
2017-01-13晚饭吃的晚,胃癌翻几番有关专家曾对30~40岁年龄组的人的饮食情况进行调查,结果发现在胃癌患者中,晚餐时间无规律者占38.4%。为什么晚饭吃的晚更容易导致胃癌高发呢?首先,胃黏膜上皮细胞的寿命很短。约2...
晚期肝癌或会发生剧痛 肝癌晚期如何饮食较好?
2017-01-131、肝区剧痛:由于肝组织长期会受到肿瘤的破坏与浸润及肝组织的局部缺血坏死等因素,导致的肝癌肝区剧痛,而肝癌晚期疼痛症状会持续加重,体制极其微弱的晚期肝癌患者可能会忍受不住疼痛,而导致出现昏厥和休克,若...
得过肠息肉更易得肠癌 平时怎样吃饭防大肠癌?
2017-01-13哪些人更容易患肠癌?1、大肠息肉患者:息肉主要分为腺瘤性和增生(炎症)性两大类。已经确知腺瘤性息肉,尤其是多个的息肉容易癌变,大肠癌在腺瘤性息肉病人中的发生率比无腺瘤的要高5倍!尤其是直径大于1厘米的...
这些东西会导致肺癌 预防肺癌吃什么好?
2017-01-13放射铀和氟石矿工接触惰性气体氡气、衰变的铀副产品等,较其他人的肺癌发生率明显要高,但是电离辐射的人员不会增加肺癌的发生。肺部慢性感染如肺结核、支气管扩张症等患者,支气管上皮在慢性感染...
纤维膳食并非越多越好 哪类食谱有益肠癌病患
2017-01-13纤维膳食并非越多越好据悉,膳食纤维分为两大类:水溶性膳食纤维和非水溶性膳食纤维。水溶性膳食纤维包括聚葡萄糖、低脂果胶、高脂果胶、低聚果糖、低聚麦芽糖等,在大麦、豆类、胡萝卜、柑橘、亚麻、燕麦...
厨房油烟会增加肺癌几率 肺癌饮食如何搭配?
2017-01-13厨房油烟威会增加患胃癌机会:说到厨房油烟,就离不开烟草,烟草里有4000多种物质,有害物质包括致癌物质有69种,在厨房烟雾中,也有200多种有害物质,包括苯并芘、挥发性的亚硝胺,都是致突变性的物质或者叫做致癌...
补对营养远离乳腺癌 营养素你吃对了吗?
2017-01-13一旦过了更年期,女性的雌激素分泌开始减少,此时更要吃饱喝足,补充足够的营养元素,从而提高身体免疫系统。1.钙钙有助于身体制造新的骨细胞,特别是对于更年期女性而言更加重要。研究表...
吃肉也能防肝癌 你知道吗?
2017-01-13研究人员对1956~2016年近50万名参试者的多项相关研究进行了综合分析。结果表明,多吃白肉(鸡肉等)和鱼肉可使原发性肝细胞癌(HCC)危险降低22%~31%。不过,研究人员表示,没有证据表明,吃红肉、加工肉类或肉类总...